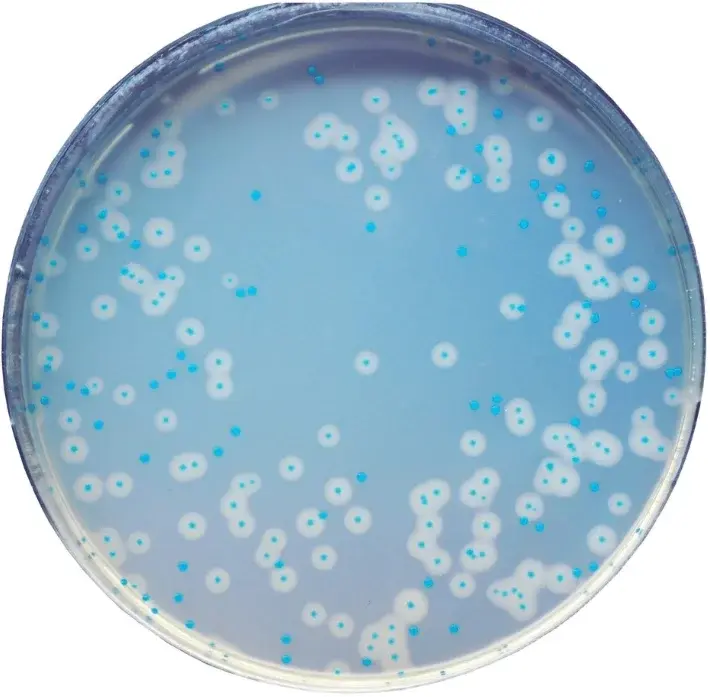
Chromagar Listeria 10 Adet

Chromagar Listeria 10 Adet
1.334,24 TL
*136,92 TL den başlayan taksitlerle!
CHROMagar Listeria 10 Adet, mikrobiyoloji laboratuvarlarında Listeria türlerini belirlemek için kullanılan yenilikçi bir besiyeridir.
Özellikleri:
- 10 adetlik paket içerisinde bulunmaktadır.
- Listeria türlerini kolayca ayırt etmek için renkli göstergeler içerir.
- Yüksek doğruluk ve güvenilir sonuçlar sağlar.
- Hızlı ve kolay uygulama imkanı sunar.
- Mikrobiyologlar tarafından güvenle kullanılan bir üründür.
CHROMagar Listeria 10 Adet ile laboratuvar çalışmalarınızı daha verimli hale getirebilir ve Listeria tespitinde hassasiyeti artırabilirsiniz.
Bu ürüne ilk yorumu siz yapın!